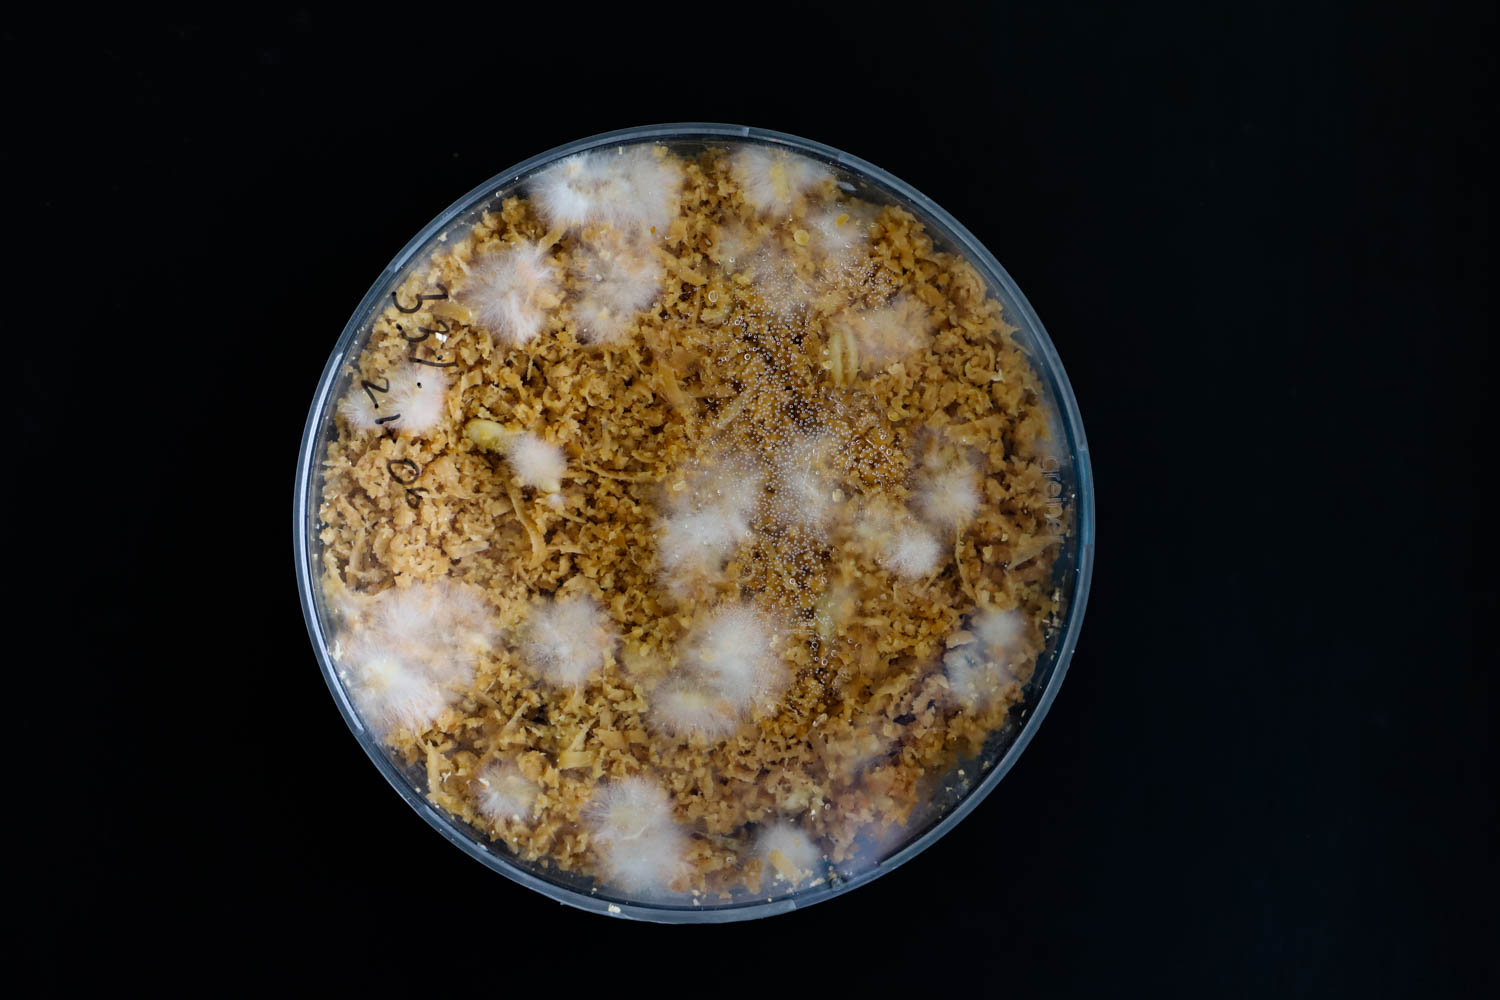
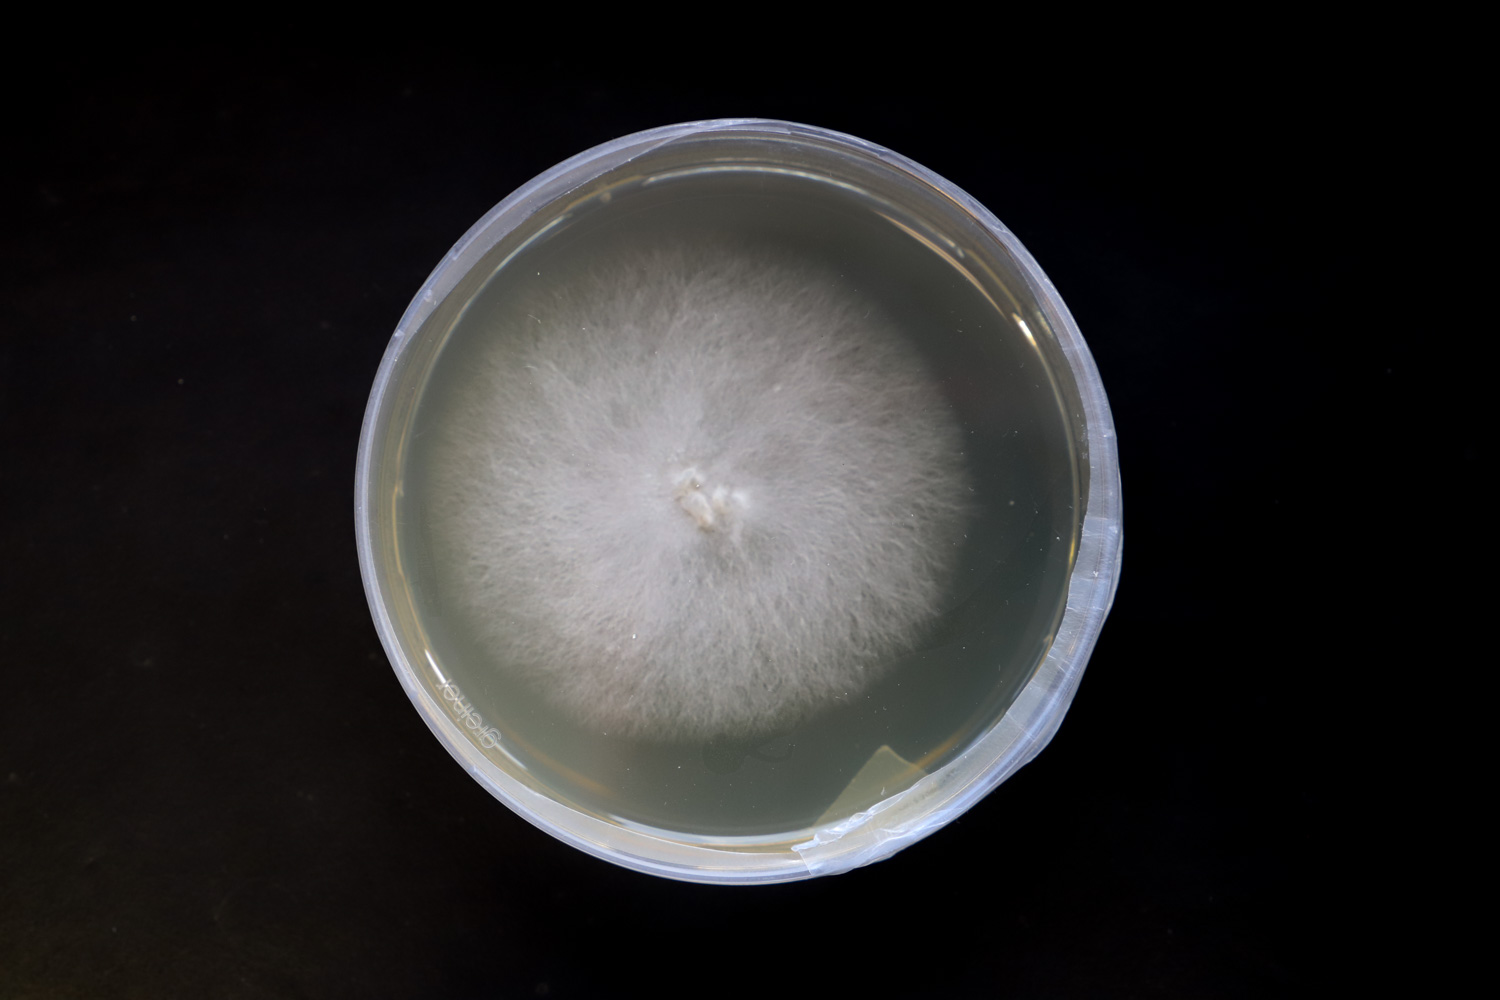
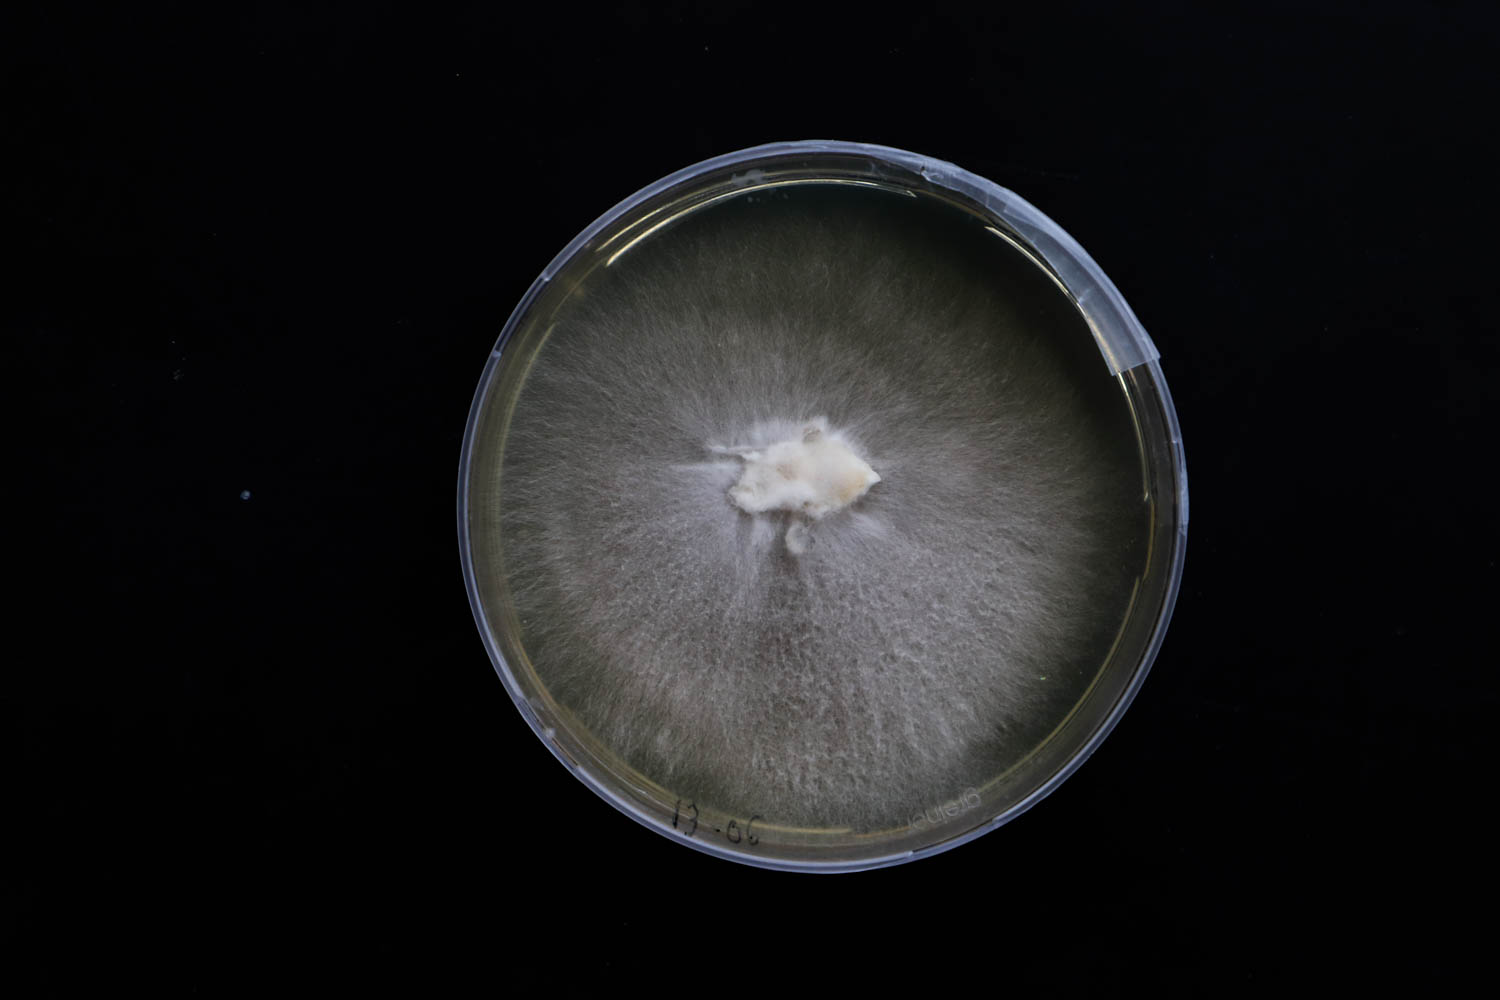

FUNGAL OBJECTS
Generously supported by: Prof. Dr. Arnd G. Heyer. Department of Plant Biotechnology, Institute of Biomaterials and Biomolecular Systems, University of Stuttgart.
2019
This project seeks the development of objects using mycelium. The mycelium is a rhizomatic network that constitutes the vegetative part of fungi. It can break down plant matter by degrading it by spreading its network of hyphae. Unlike conventional materials, this material grows and, therefore, has a different development process. When combined, the mycelium obtains nutrients from the substrate to grow and through this process binds all loose particles around it creating a composite material. Due to its natural ability to fuse very small pieces of organic material into a larger whole, this material can obtain qualities similar to polystyrene foam and other plastics that are used in various oil and water based industries. Mycelium in particular can be generated from local species and raw materials, representing an attractive alternative to traditional synthetic products, since it is 100% natural, fully compostable and resulting from waste streams.
The entire process and methods of growth are published here.

KAPHEND 2025 — Planet Earth